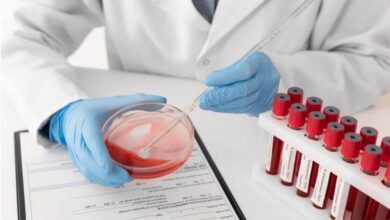

जनगणना 2027 की शुरुआत 1 अप्रैल से, पहले चरण में घर-घर पहुंचेंगे कर्मचारी, जानिए क्या होगा जिनके पास कई घर हैं

नई दिल्ली
7 जनवरी 2026 को केंद्रीय सरकार ने भारतीय जनगणना2026 का नोटिफिकेशन जारी कर दिया है. ये दो चरणों में होगा. पहले चरण में 1 अप्रैल देशभर में मकानों को लिस्ट में दर्ज किया जाएगा. ये काम केंद्र सरकार के रजिस्ट्रार जनरल और जनगणना आयुक्त आफिस के जरिए होगा. इस सर्वे को लेकर कई सवाल लोगों की जेहन में हो सकता है जैसे मकान में आकर क्या क्या पूछा जाएगा. अगर आपके कई मकान हैं तो उसका क्या असर होगा. अगर आप किराएदार हैं तो मकान दर्ज करने आए कर्मचारी क्या जानेंगे.
भारत का रजिस्ट्रार जनरल और जनगणना आयुक्त हर बार जनगणना का काम करता है. इस बार भी यही विभाग ये काम करेगा. ये विभाग गृह मंत्रालय के अधीन काम करता है. इसमें ये ना केवल योजना बनाता है बल्कि डेटा जुटाता है और इसको प्रोसेस भी करता है. इससे संबंधित ट्रेनिंग और पब्लिकेशन का काम भी उसका है. इसका विभाग के मौजूदा आयुक्त मृत्युंजय कुमार नारायण हैं. यह कार्यालय 1950 के दशक से स्थायी रूप से अस्तित्व में है. इसमें राज्य स्तर के निदेशालय मिलकर काम करते हैं.
2027 की जनगणना में कई नई चीजें और कई नई बातें शामिल की जा रही हैं. जैसे ये जनगणना डिजिटल होगी. इसमें ऐप, सेल्फ-एनुमरेशन और जाति गणना शामिल है.
सवाल – जनगणना 2027 का नोटिफिकेशन जारी कर दिया गया है. इसके पहले दौर में क्या होगा. जिसे हाउस लिस्टिंग ज्यादा कहा जा रहा है?
– भारत की जनगणना एक बड़ी प्रशासनिक और सांख्यिकीय प्रक्रिया है, जो हर 10 साल में होती है. हालांकि इस बार ये 5-6 साल के विलंब से हो रही है. इसकी वजह COVID-19 महामारी रही. पहला चरण हाउस लिस्टिंग और हाउसिंग जनगणना का होगा, जो 1 अप्रैल से 30 सितंबर 2026 तक चलेगी.
दूसरा चरण जनसंख्या गणना का होगा, जो फरवरी 2027 में होगा. इस काम में पूरे देश में 30 लाख लोगों को काम में लगाया जाएगा.
सवाल – क्यों आपका घर पहले दौर में दर्ज होगा?
– पहले चरण का फोकस घरों की सूची बनाना है, ताकि दूसरे चरण में जनसंख्या गणना के लिए एक मजबूत फ्रेमवर्क तैयार हो सके. इससे पता चलता है कि देश में कितने घर हैं, उनकी स्थिति कैसी है. वहां कौन-कौन सी सुविधाएं उपलब्ध हैं.
इस चरण में घर को लिस्ट में दर्ज करने के साथ घर की स्थिति यानि कच्चा या पक्का, सुविधाएं यानि जल, बिजली, शौचालय आदि दर्ज होंगी. फिर इसी के साथ ये भी दर्ज होगा कि आपके पास घर में कौन सी संपत्तियां हैं यानि टीवी, कार आदि. ये डेटा सरकार को नीतियां बनाने में मदद करता है, जैसे गरीबी उन्मूलन, आवास योजनाएं और संसाधनों का वितरण.
सवाल – क्या जनगणना राष्ट्रीय जनसंख्या रजिस्टर का काम भी करेगा?
– हां, ऐसा ही होगा. ये राष्ट्रीय जनसंख्या रजिस्टर (NPR) को अपडेट करने में भी मदद करेगा. बिना घरों की सूची के, जनसंख्या गणना अधूरी रह जाएगी, इसलिए ये घर घर जाकर की जाएगी.
सवाल – पहले दौर में क्या-क्या होगा?
– जनगणना कर्मचारी आपके घर आएंगे. उनके साथ सवालों की एक लिस्ट होगी, ये आपके घर से संबंधित जानकारियों को हासिल करने के लिए होगी. ये काम 30 दिनों के भीतर पूरा होना है. इस बार सरकार हर किसी को भी ये विकल्प दे रही है कि वो अपने घर की जानकारी खुद आनलाइन भर सकें. ये सुविधा जनगणना साइट पर 15 मार्च से उपलब्ध हो जाएगी. आप Census ऐप या पोर्टल (https://se.census.gov.in/) पर जाकर रजिस्टर कर सकते हैं.
जनगणना कर्मचारी और अधिकारी टैबलेट या ऐप से डेटा भरेंगे, जो रियल-टाइम मॉनिटरिंग के लिए सेंट्रल पोर्टल पर अपलोड होगा. इससे डेटा की गुणवत्ता बेहतर होगी.
सवाल – जब जनगणना स्टाफ आपके घर आएगा तो क्या जानकारी लेगा?
– घर कैसा है. पक्का/कच्चा, कितने कमरे. मालिकाना हक – किराए का या अपना या किसी और का. अगर घर खाली है, तो उसे ‘वैकेंट’ के रूप में नोट किया जाएगा. ये भी देखा जाएगा कि घर का उपयोग आवासीय है या व्यावसायिक या फिर मिक्स्ड.
सुविधाएं – पीने का पानी, बिजली, शौचालय, किचन, ईंधन (गैस, लकड़ी).
संपत्तियां – टीवी, फ्रिज, कार, बाइक, इंटरनेट आदि.
सवाल – पहले चरण की जनगणना में क्या नहीं होगा?
– इस चरण में व्यक्तिगत जनसंख्या डेटा नहीं ली जाएगी. मसलन आपका या परिवार के लोगों का नाम, उम्र, लिंग. ये काम दूसरे चरण में होगा.
सवाल – जिनके पास कई घर हैं, उनका क्या होगा?
– जनगणना का ये पहला चरण केवल घरों की गिनती कर रहा है ना कि मालिकों की गिनती. अगर आपके पास कई घर हैं तो हर घर को अलग-अलग सूचीबद्ध किया जाएगा.
अगर किसी ने अपने घर को किराए पर उठा दिया है तो किराएदार की जानकारी ली जाएगी. अगर खाली है तो उसे वैकेंट मार्क किया जाएगा लेकिन फिर भी उसकी सुविधाओं का डेटा तो लिया ही जाएगा. कई घर होना कोई समस्या नहीं है. जनगणना टैक्स या संपत्ति जांच के लिए नहीं है. आपका डेटा केवल सांख्यिकीय उद्देश्यों के लिए इस्तेमाल होगा, न कि व्यक्तिगत जांच के लिए.
सवाल – आपके घर कौन आएगा?
– जनगणना के लिए राज्य सरकार या स्थानीय प्रशासन के नियुक्त कर्मचारी. ये ज़्यादातर शिक्षक, पटवारी, आंगनवाड़ी सुपरवाइज़र, नगर निगम, पंचायत के कर्मचारी होते हैं. इनके पास सरकारी पहचान पत्र, जनगणना का ऑथराइजेशन लेटर होगा. आपको उनकी ID देख लेने का पूरा हक़ होगा.
सवाल – अगर आप सहयोग नहीं करें तो क्या होगा?
– जनगणना संविधानिक और कानूनी प्रक्रिया है. जानबूझकर गलत जानकारी देना या पूरी तरह मना करना दंडनीय है और जनगणना अधिनियम, 1948 के तहत अपराध है. अगर आपने असहयोग किया तो जुर्माना लगाया जा सकता है.
सवाल – क्या जनगणना का डेटा “कानूनी दस्तावेज” होता है?
-नहीं. जनगणना कतई कानूनी दस्तावेज नहीं होती. आप जनगणना की एंट्री दिखाकर यह नहीं कह सकते कि सरकार ने मान लिया है कि मैं यहीं का निवासी हूं. इसमें कोई दस्तावेज़ सत्यापन के लिए नहीं होता.
सवाल – फिर जनगणना किस तरह कानूनी या सरकारी कामों में काम आती है?
– नीति और कानून बनाने में. लोकसभा/विधानसभा सीटों के परिसीमन में. नगर निकायों और पंचायतों की सीमा तय करने में. आरक्षण आंकड़ों में.
सवाल – अगर जनगणना वाले घर आए और आप नहीं मिले. घर बंद मिला तो…?
– यह एक बहुत आम और व्यावहारिक स्थिति है. जनगणना प्रणाली इसके लिए पहले से तैयार रहती है. इसमें घबराने की कोई वजह नहीं होती. पहली बार घर बंद मिला तो कर्मचारी घर बंद की अस्थायी नोटिंग करता है. दरवाजे पर अक्सर स्टिकर, चाक मार्क या स्लिप लगा देता है. पड़ोसी के पास सूचना छोड़ी जाती है. इसे असफल गणना नहीं माना जाता. जनगणना कर्मचारी दोबारा और तीसरी बार भी आएंगे. जनगणना के नियमों के मुताबिक हर घर में कम-से-कम 2–3 बार अलग-अलग समय पर आने की कोशिश होती है. सुबह, दोपहर या शाम – ताकि कामकाजी लोग भी मिल सकें. वैसे कई बार पड़ोसी से पूछताछ करके सतही जानकारी ले ली जाती है. अगर लंबे समय तक घर बंद रहे यानि कई सप्ताह और महीनों तो मकान को खाली या अस्थायी तौर पर बंद मकान के रूप में दर्ज किया जा सकता है. कानूनी दिक्कत तभी होती है जब आप मौजूद होते हुए भी जानबूझकर इनकार करें.